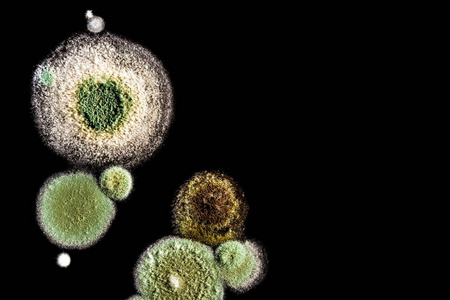
绿色霉菌在变质食品上的传播, 通过显微镜观察

【50种典型细菌真菌霉菌套装生物医学微生物
200x200 - 6KB - JPEG

宝妈个人主页
958x882 - 116KB - JPEG
绿色霉菌在变质食品上的传播, 通过显微镜观察
450x300 - 36KB - JPEG

太恐怖!汽车空调里住着霉菌、尘螨、细菌、真
611x404 - 54KB - JPEG

显微镜下的人体细菌图片
906x650 - 139KB - JPEG

几种霉菌在显微镜下的形态特征图片一组
450x360 - 22KB - JPEG

太恐怖,原来我们的汽车空调系统里住着霉菌、
632x476 - 49KB - JPEG

显微镜下霉菌(黑曲霉、根霉、青霉)形态观察图
1080x810 - 38KB - JPEG

绿色霉菌在变质食品上的传播, 通过显微镜观察
450x300 - 117KB - JPEG

绿色霉菌在变质食品上的传播, 通过显微镜观察
450x300 - 109KB - JPEG
知生活|梅雨天气巧防霉,莫叫梅雨变霉雨 - 今日
554x386 - 27KB - JPEG

霉病,霉属,霉菌,显微镜
1200x801 - 1432KB - JPEG

粘液霉菌的孢子。显微镜
1024x767 - 152KB - JPEG

绿色霉菌在变质食品上的传播, 通过显微镜观察
450x300 - 104KB - JPEG

高清:实拍电子显微镜下毛骨悚然的牙齿细菌
687x515 - 152KB - JPEG